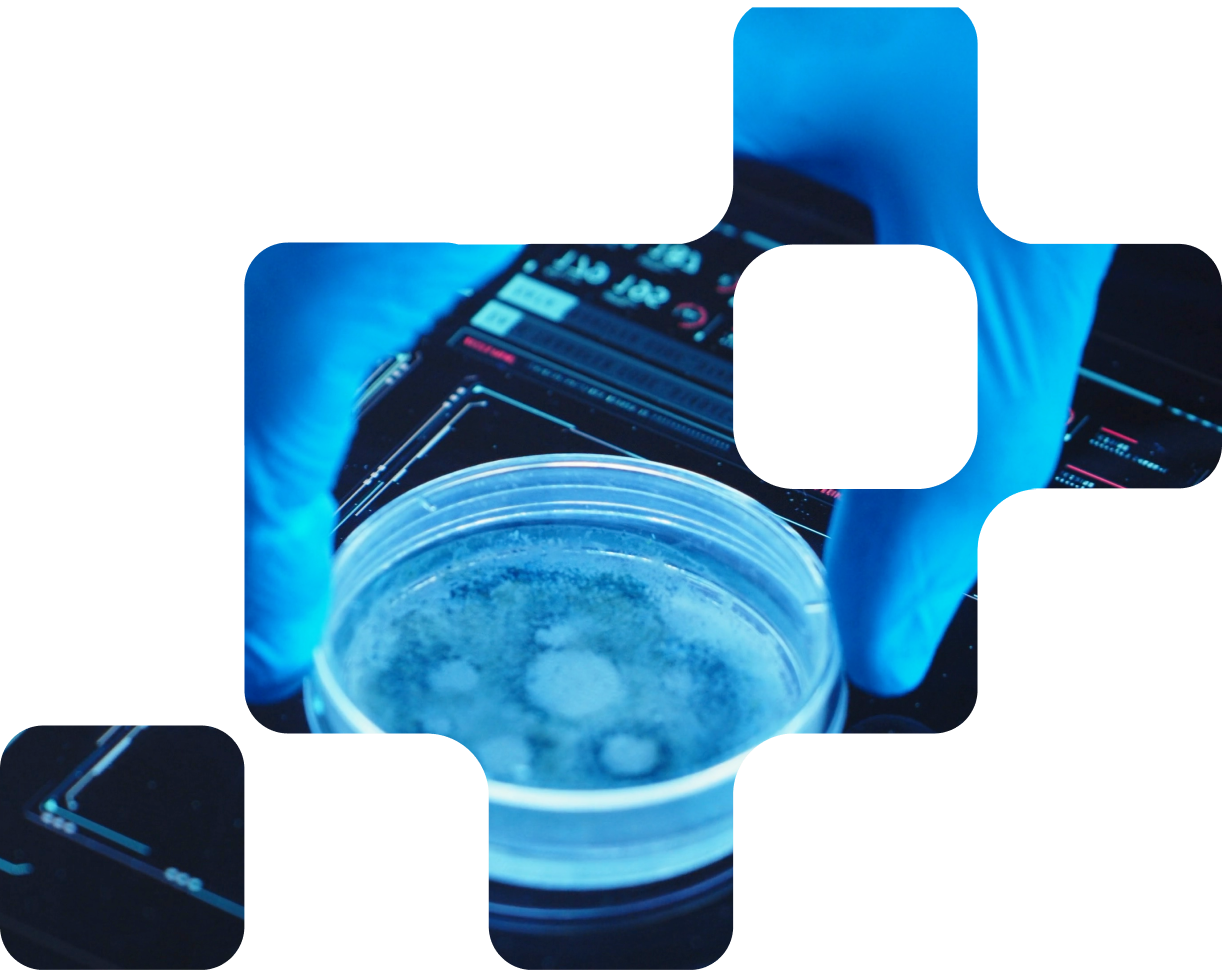

Join the Healthspan Future
Join the European Longevity Hub - the premier acceleration program for visionary founders in longevity and health-tech.
Is European Longevity Hub the right fit for your journey? Here’s what we look for.
Early Detection
& Prevention
Startups developing tools that detect health risks at the earliest stage, enabling proactive interventions and reducing the burden of late-stage disease.
Regenerative
& Cellular
Biotechs pioneering breakthroughs in cellular rejuvenation, tissue repair and stem cell science with the potential to transform healthcare at its core.
Personalized
Medicine
Companies leveraging genomics, multi-omics and AI-driven analytics to design therapies, diagnostics and care pathways tailored to individual biology.
Digital Health
& Monitoring
Startups creating platforms for continuous remote care, predictive health insights and AI-powered support that keep people connected to their health in real time.
Healthspan
Optimization
Innovators focused on extending the years of vitality, independence and wellbeing, ensuring people live better as they live longer.
Consumer Health
& Wellness
Supplements, nutrition, fitness, skincare and next-generation wellness brands that empower individuals to take ownership of their health.

Early stage companies
Two Tracks Driving a Shared Mission: Extend Lifespan
European Longevity Hub provides two tailored tracks designed to accelerate early-stage longevity startups on their journey to impact.
1. From Lab to Launch
12–18+ months / Scientific validation
For early-stage, pre-clinical startups advancing therapeutics, diagnostics, and science-driven breakthroughs in longevity.
▶ Access to specialised labs and advanced equipment
▶ IP strategy and patent guidance
▶ Clinical trial design and regulatory support
▶ Tailored fundraising for biotech ventures

2. Scaling Health-Tech
4 months / rapid iteration
For product-ready startups to secure data access, run pilot deployments, and move fast from validation to market.
▶ AI data access for training and validation
▶ Clinical pilots with trusted partners
▶ User testing and rapid feedback
▶ Go-to-market strategy and scaling support

Your strategic partner
for lasting impact.
mature companies
Custom programmes for established ventures seeking growth and European expansion, or access to our ecosystem. Beyond acceleration, a strategic partner in your journey
Custom Solutions for Mature Companies
If your longevity company does not fit our standard tracks, we design personalised pathways to support your European expansion goals.
Soft Landing Programs
Seamless market entry with regulatory guidance and trusted local partners.
Strategic Partnerships
Access to our network of healthcare organisations and industry leaders.
Market Access
Tailored go-to-market strategies and distribution channel development.
Deal-by-Deal Basis
Flexible engagement models shaped to your specific needs and timelines.
four pillars powering the European Longevity Hub programme

Clinical Access
Direct access to real-world validation, clinical data and physician feedback.

Market Integration
Fast commercialization via partnerships, pilots and go-to-market support.

World-Class Mentorship
Multi-layered guidance from venture partners, industry experts and peers.

Validation Focus
Evidence-based growth built on scientific proof and measurable traction.

Step-by-Step Journey
Join our simple, multi-phase application process and take the first step toward transforming longevity.
Application Deadline: FEB/26
-
Submit your initial application.
-
Provide detailed information about your project.
-
Participate in an interview and evaluation.
-
Choose the programme track that fits your startup.
-
Begin your journey with an in-person launch event.
-
We take a founder-friendly approach to equity, typically between 6–15%, in exchange for our full support. This includes mentorship from seasoned experts, access to our network of partners and investors, and the resources needed to accelerate growth. Each agreement is tailored to the specific stage and needs of the startup.
-
Applications close January 2026. The programme begins with a kickoff in Lisbon, followed by the track timelines: 4–6 months for Digital Health & AI and 12–18+ months for Biotech & Life Science
-
We welcome passionate founders advancing longevity and health-tech solutions. Biotech track startups are typically early-stage and pre-clinical, while Digital Health ventures are product-ready and preparing for scaling and market validation.
-
Graduates join a lifelong network of peers, mentors, and partners. You’ll continue to access expert guidance, partnership opportunities, follow-on funding connections, and ongoing strategic support as you grow your company.
Frequently Asked Questions

Apply to Our Ecosystem
Leave your details to explore how european longevity hub can help you scale
This is the first step in our selection journey. After reviewing your submission, selected startups will be invited to complete a full application with more details on your team, traction, and vision.